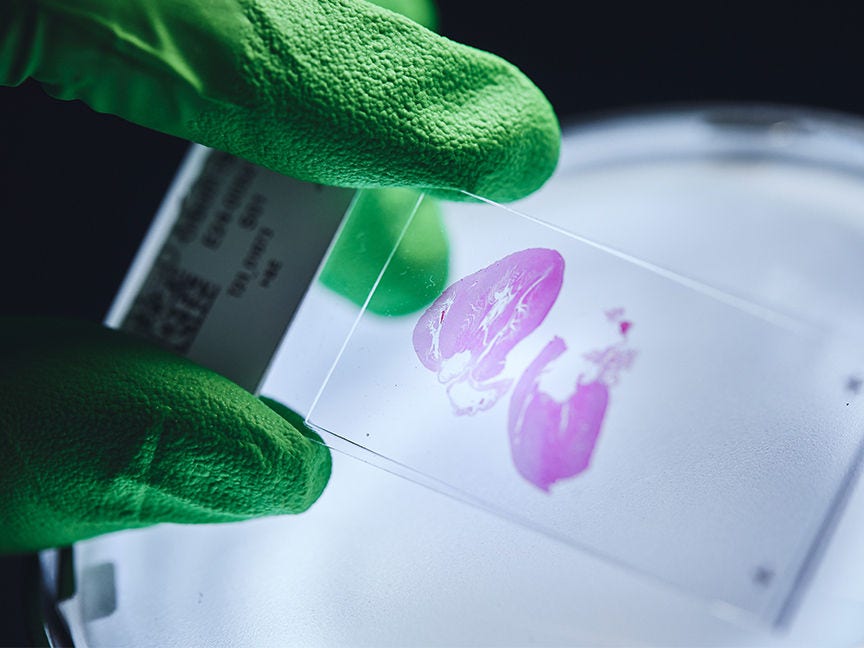

Unsere wissenschaftliche Grundlagenforschung
Wir bereiten den Weg für die Medizin der Zukunft
BioNTechs bahnbrechende Forschung im Bereich der Boten-RNA (messenger RNA, „mRNA“) ebnete den Weg, um das weltweit erste zugelassene mRNA-basierte Medikament zu entwickeln. Nachdem der ursprüngliche Fokus der BioNTech-Mitgründer, Ugur Sahin und Özlem Türeci, auf der Entwicklung von mRNA-basierten Krebsimmuntherapien lag, haben sie inzwischen ein diversifiziertes Portfolio aufgebaut, das verschiedene therapeutische Modalitäten umfasst, um Krebs sowie Infektions- und andere schwerwiegende Erkrankungen zu adressieren.
Wir treiben Fortschritte voran: BioNTechs Innovationen im Bereich der mRNA-Forschung
Bei der Optimierung von mRNA für die Entwicklung von Krebsimmuntherapie-Kandidaten musste BioNTech drei große Herausforderungen stellen, die zuvor als unüberwindbar galten:

mRNA-Krebsimmuntherapien mussten so wirksam sein, dass sie eine große Anzahl von Immunzellen aktivieren können, da selbst kleine Tumore aus Millionen von Krebszellen bestehen.
Die Eigenschaften von Tumoren sind individuell und unterscheiden sich für jede einzelne Patientin und jeden einzelnen Patienten. Dies erforderte einen anpassbaren Ansatz, mithilfe dessen mRNA-Krebsimmuntherapien auf das individuelle Antigenprofil jeder Patientin und jedes Patienten zugeschnitten werden können.

Die schnelle Herstellung dieser individualisierten mRNA-Krebsimmuntherapien war entscheidend, um das Fortschreiten der Krebserkrankung effektiv zu bekämpfen.
Über zwei Jahrzehnte hinweg erzielten Ugur Sahin, Özlem Türeci und ihre Teams bedeutende wissenschaftliche und technologische Durchbrüche, um das volle Potenzial von mRNA für die Krebsimmuntherapie zu erschließen:
Sie optimierten die strukturellen Komponenten der mRNA – wie die Kappe, den Poly-A-Schwanz und ihre nicht-translatierten Regionen – um die intrazelluläre Stabilität der mRNA und die Effizienz der Antigen-Translation zu verbessern und steigerten ihre Expression um mehr als das 1.000-Fache.
Sie verbesserten die Wirksamkeit von mRNA-Krebsimmuntherapie-Ansätzen, indem sie Mechanismen der selektiven mRNA-Aufnahme in dendritischen Zellen entdeckten - insbesondere in lymphatischen Geweben, in denen Immunzellen gebildet, aktiviert und koordiniert werden. Auf diese Weise können stärkere Immunantworten hervorgerufen werden.
Sie identifizierten eine Methode zur Verbesserung der Antigenpräsentation durch dendritische Zellen für stärkere T-Zell-Antworten, indem sie die Antigene mit einem Major Histocompatibility Complex I (MHC-I)-Transportsignal koppelten.
Auf der Grundlage aller oben genannten Entdeckungen entwickelten sie einen individualisierten mRNA-Immuntherapie-Ansatz, der potenziell an verschiedene Krebsarten angepasst werden und innerhalb weniger Wochen für den Einsatz in klinischen Studien hergestellt werden kann.
Vielfältige Ansätze zur Optimierung von mRNA
Über mehrere Jahre hinweg lösten Ugur Sahin, Özlem Türeci und andere Forschende weltweit grundlegende Probleme im Zusammenhang mit RNA-basierten Medikamenten mithilfe verschiedener Ansätze. Zu den größten Herausforderungen zählten die Minimierung von Entzündungen aufgrund von Immunantworten durch hohe Dosierungen und die Verbesserung der Proteinproduktion.1,2
Forschende, die sich auf mRNA-Therapien zur Behandlung von Schlaganfällen und Gehirnerkrankungen konzentrierten, entdeckten, dass der Ersatz des Uridin-Nukleotids in der mRNA mit einer natürlich vorkommenden Alternative wie Methylpseudouridin die RNA-bedingte Immunaktivierung und Entzündungsreaktion unterdrückte3,4, wodurch höhere Dosierungen der Behandlung möglich wurden5.
Ugur Sahin und Özlem Türeci verfolgten einen anderen Ansatz, indem sie Designs für die strukturellen Komponenten der mRNA entwickelten6,7. Diese erhöhten die intrazelluläre Stabilität und Translationseffizienz, insbesondere in Immunzellen8. Hierdurch konnte nun bereits durch niedrigere Dosen eine maßgebliche, starke Immunantwort induziert werden. Die mRNA wurde damit potent genug, um im pharmazeutischen Sinne eingesetzt zu werden9,10.
Wir optimieren mRNA: Strukturelle Verbesserungen, mit dem Ziel, das volle Potenzial der mRNA zu nutzen
5’-Cap-Struktur
Durch die Verwendung eines einzigartigen Cap-Analogons verbesserten Sahin und Türeci die Translationsleistung, stabilisierten das mRNA-Molekül und ermöglichten eine zielgerichtetere Immunantwort.
Nicht-translatierte Region am 3‘-Ende
Die Zusammensetzung und strukturellen Innovationen der nicht-translatierten Regionen am 3‘-Ende von Sahin und Türeci sind entscheidend für die Gewährleistung der intrazellulären Stabilität der mRNA.
Poly-(A)-Schwanz
Durch umfangreiche Erforschung der Struktur des Poly-(A)-Schwanzes und der Translationseigenschaften von mRNA haben Sahin und Türeci maßgeschneiderte mRNA-Template-Designs entwickelt.
mRNA Formate
Bei der Anwendung zur Produktion therapeutischer Proteine, wie es bei unseren RiboMab- und RiboCytokine-Plattformen der Fall ist, müssen wir immunogene Reaktionen gegen mRNA-Wirkstoffe vermeiden. BioNTech besitzt umfangreiche Erfahrung beim Einbau natürlich vorkommender modifizierter Nukleoside in unsere therapeutischen mRNAs. Wir konnten nachweisen, dass der Einbau verschiedener modifizierter Nukleoside in die hergestellte mRNA deren intrinsische Immunaktivierung unterdrückte und gleichzeitig im Laufe der Zeit zu einer besseren Proteinproduktion führte. Die sogenannte De-Immunisierung der mRNA durch den Einbau modifizierter Nukleoside hilft dabei, die Bildung von Antikörpern gegen den Wirkstoff selbst zu vermeiden und erweitert so die therapeutische Anwendung dieser Arten von mRNA-Wirkstoffen.
Unsere präklinischen saRNA-Kandidaten nutzen das Konzept der viralen Replikation, wobei sie selbst nicht infektiös oder krankheitserregend sind. saRNA ähnelt unserem konventionellen mRNA-Ansatz zur Kodierung für ein bestimmtes Protein, kodiert aber zusätzlich für eine Polymerase, Replikase genannt, die einen Teil der mRNA innerhalb der Zielzelle vervielfacht. Während dieser Selbstamplifizierung innerhalb der Zelle entsteht ein doppelsträngiges RNA-Zwischenprodukt, das von intrazellulären Immunsensoren erkannt wird. Aus diesem Grund ist saRNA ein sehr starker Aktivator des Immunsystems und somit ein hervorragender Immuntherapieansatz.
Diese Technologie ist eine Weiterentwicklung der saRNA-Plattform. Durch die Trennung der zu vervielfältigenden Ziel-mRNA von der für die Replikase kodierenden mRNA können wir zusätzliche Anwendungen entwickeln. Dies macht die Entwicklung von therapeutischen mRNAs noch flexibler, da die Replikase mRNA-Sequenzen amplifizieren kann, die für mehrere unterschiedliche Proteine kodiert. Somit können wir die Replikase bereits im Voraus produzieren und dann in unterschiedlichen Impfstoffkandidaten nutzen. Unsere transamplifizierende mRNA ist ein unternehmenseigenes mRNA-Format, von dem wir glauben, dass es sich sehr gut für prophylaktische Impfstoffe zur Vorbeugung von Infektionskrankheiten eignet.
Wirkstoffformulierungen
BioNTech hat große Durchbrüche bei der Entwicklung ihrer Krebsimmuntherapiekandidaten sowie mRNA-Impfstoffansätzen gegen Infektionserkrankungen erzielt. Die Entwicklung von geeigneten Formulierungen für Lipid-Nanopartikel für den sicheren und gezielten Transport von mRNA ist dabei ein wichtiger Meilenstein. Ugur Sahin und Özlem Türeci entdeckten einen Mechanismus der selektiven mRNA-Aufnahme in dendritische Zellen und entwickelten zusammen mit ihrem Team eine Formulierung für einen Lipid-Nanopartikel, der diesen Mechanismus nutzt, um RNA gezielt in diese Zellen zu transportieren.
BioNTech nutzt derzeit verschiedene Formulierungen für den mRNA-Transport, die jeweils auf bestimmte Funktionen zugeschnitten und entsprechend der Anwendungs- und Verabreichungsart optimiert sind:
Für andere Anwendungen verkapseln wir unsere mRNA in Lipid-Nanopartikel oder LNPs. Diese Formulierungen eignen sich für unsere RiboMab- und RiboCytokine-Plattformen. LNPs kommen auch bei unserem COVID-19-Impfstoff zum Einsatz.
Unser Portfolio umfasst außerdem Polyplexe, die in einigen unserer Forschungsprogramme verwendet werden. Dort wird die mRNA an ein Polymer gebunden und bildet Nanopartikel.
Mehr entdecken

Globale Gesundheit

Investoren

Karriere
Quellen
1 Karikó K et al., Incorporation of Pseudouridine Into mRNA Yields Superior Nonimmunogenic Vector With Increased Translational Capacity and Biological Stability. Molecular Therapy (2008)
2 Karikó K et al., Suppression of RNA recognition by Toll-like receptors: the impact of nucleoside modification and the evolutionary origin of RNA. Immunity (2005)
3 Karikó K et al., Incorporation of Pseudouridine Into mRNA Yields Superior Nonimmunogenic Vector With Increased Translational Capacity and Biological Stability. Molecular Therapy (2008)
4 Karikó K et al., Suppression of RNA recognition by Toll-like receptors: the impact of nucleoside modification and the evolutionary origin of RNA. Immunity (2005)
5 Karikó K et al., Suppression of RNA recognition by Toll-like receptors: the impact of nucleoside modification and the evolutionary origin of RNA. Immunity (2005)
6 Holtkamp S et al., Modification of antigen-encoding RNA increases stability, translational efficacy, and T-cell stimulatory capacity of dendritic cells. Blood (2008)
7 Kuhn AN et al., Phosphorothioate cap analogs increase stability and translational efficiency of RNA vaccines in immature dendritic cells and induce superior immune responses in vivo. Gene Therapy (2010)
8 Kreiter S et al., Increased Antigen Presentation Efficiency by Coupling Antigens to MHC Class I Trafficking Signals. The Journal of Immunology (2008)
9 Verbeke R et al., Three decades of messenger RNA vaccine development. Nano Today (2019)
10 Sahin U et al., mRNA-based therapeutics - developing a new class of drugs. Nature Reviews Drug Discovery (2014)